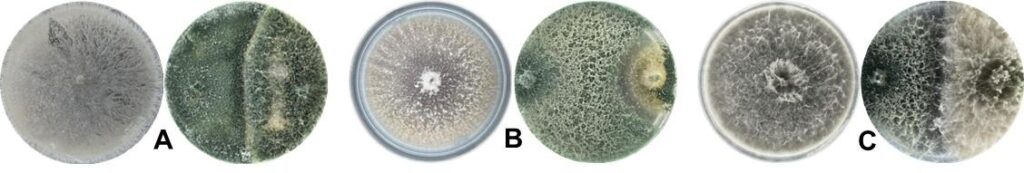

A preocupação com o meio ambiente, e a busca por cultivo mais sustentável, levaram a estudos mais aprofundados por pesticidas biológicos ou biopesticidas para o combate às pragas, e descobriram que o fungo Trichoderma possui a multifuncionalidade perfeita para o controle biológico.
Reunimos neste artigo informações importantes sobre o uso do Trichoderma , e os benefícios para o meio ambiente.
O que são Trichoderma?
É um gênero de fungo filamentoso que têm ganhado destaque por suas versáteis aplicações em diversas áreas, principalmente na agricultura. A eficácia do Trichoderma é atribuída aos seus diversos mecanismos de ação. Vamos abordar alguns dos principais mecanismos de ação do Trichoderma:
Competição e a colonização
É um excelente colonizador de raízes de plantas, ocupando a rizosfera ou filosfera, criando uma vantagem competitiva sobre os fitopatógenos (microrganismos infecciosos). Cresce rapidamente e forma uma barreira protetora, impedindo o estabelecimento de patógenos na superfície da planta e na zona radicular.
Antibiose e antagonismo
Produz uma larga escala de metabólitos secundários (compostos orgânicos), incluindo antibióticos, enzimas líticas e compostos orgânicos voláteis. Esses compostos exibem atividades antagônicas contra vários patógenos de plantas, como bactérias, fungos e nematóides. Os antibióticos secretados pelo Trichoderma inibem o crescimento e desenvolvimento de patógenos, enquanto as enzimas líticas degradam suas paredes celulares, levando à sua análise (Figura 1).
Estimula o sistema de defesa
Estimula os mecanismos de defesa da planta através da indução de resistência sistêmica. Ele desencadeia uma cascata de reações bioquímicas na planta, levando à produção de compostos relacionados à defesa. Esse mecanismo ajuda as plantas a suportar estresses bióticos e abióticos, incluindo ataques de patógenos.
Promoção do crescimento das plantas
É conhecido por sua capacidade de solubilizar formas insolúveis de nutrientes, como o fósforo. Ele libera enzimas, como fosfatases, que decompõem compostos orgânicos complexos ou formas minerais de nutrientes em formas solúveis mais simples, para que as plantas possam absorver prontamente. Isso aumenta a disponibilidade e absorção de nutrientes pelas plantas, promovendo seu crescimento e desenvolvimento.
Produção de hormônio promotor de crescimento
O Trichoderma produz hormônios promotores de crescimento de plantas, incluindo auxinas e giberelinas. Esses hormônios estimulam o alongamento da raiz, a formação da raiz lateral e o crescimento geral da planta. Eles também desempenham um papel no aumento da eficiência de absorção de nutrientes, absorção de água e tolerância ao estresse nas plantas.
Decomposição e Ciclagem de Nutrientes
É um eficiente decompositor de matéria orgânica, decompondo compostos orgânicos complexos em formas mais simples e liberando nutrientes de volta ao solo. Isso contribui para a ciclagem de nutrientes e a manutenção da fertilidade do solo. Além disso, o processo de decomposição realizado pelo Trichoderma contribui para o sequestro de carbono e mitiga as emissões de gases de efeito estufa.
Conclusão
Espécies pertencentes ao gênero Trichoderma exercem efeitos benéficos através de uma combinação de competição, antagonismo, resistência induzida, solubilização de nutrientes, produção de hormônios e atividades de decomposição.
Ao contrário dos pesticidas convencionais, os biopesticidas como o Trichoderma são seguros para o meio ambiente, não deixam resíduos tóxicos e não prejudicam os organismos orgânicos, como insetos polinizadores.
Esses mecanismos contribuem coletivamente para o controle biológico de patógenos de plantas, promoção do crescimento e sustentabilidade em sistemas agrícolas, tornando o Trichoderma uma ferramenta valiosa para agricultura sustentável e gestão ambiental.